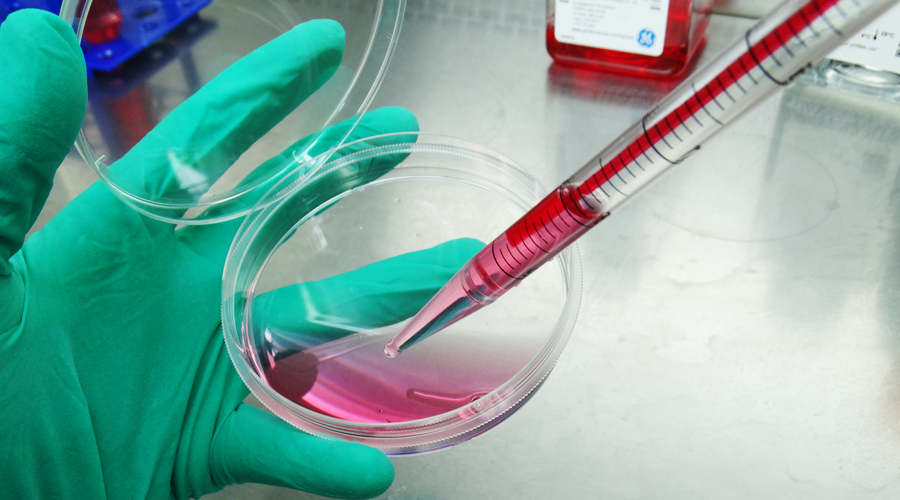
新闻图片3

上海宇玫博生物科技有限公司品牌商
9 年
手机商铺
商家活跃:
产品热度:
- NaN
- 0
- 1
- 2
- 1
外泌体专用无血清培养基
¥2200
品牌商
上海宇玫博生物科技有限公司
入驻年限:9 年
- 联系人:
宇玫博
- 所在地区:
上海 浦东新区
- 业务范围:
技术服务、耗材、实验室仪器 / 设备、细胞库 / 细胞培养、论文服务、试剂、原辅料包材
- 经营模式:
生产厂商 经销商 科研机构
公司新闻/正文
外泌体专用无血清培养基暑期特惠活动来啦!
825 人阅读发布时间:2022-07-22 17:20
夏日炎炎,有你超甜。最近很多新老客户问外泌体专用无血清培养基的活动还有没有,小编说可以有,而且还升级了!
首先,外泌体专用无血清培养基目前客户主要应用范围是肿瘤细胞和T细胞,也有一些客户的间充质干等细胞的文章也陆续出来了。更多的应用在增加,更多的文献在发表,我们的活动也要跟上客户的脚步,我们是新时代摸着石头过河的新青年,7年得外泌体发展历程,让我们脚步愈加稳健!
 客户用我们的外泌体专用无血清培养基有三大好处:
客户用我们的外泌体专用无血清培养基有三大好处:
1:节省成本:相比于还要买无外泌体血清,成本更低,类似于完全培养基的状态;
2:节省时间:不管是半换液还是直接全换液,都是比较方便使用的,不需要再用FBS去配置;
3:真正做到没有外泌体干扰:完全没有胎牛血清来源外泌体的干扰,科研数据更加严谨可靠,电镜背景更干净,提取出的外泌体杂蛋白更少,PS:因为有很多客户反馈无外泌体血清培养的外泌体在提取纯化过柱子的时候会堵柱子。
 活动升级:
活动升级:
Umibio很贴心的为大家准备了几款可以用于相关实验的小试剂,帮您一箭双雕。
做探索:GW4869抑制剂,用于抑制外泌体的产生,配置好了,直接用,因为很多客户反馈自己在配置的时候老是溶解不好;
做鉴定:外泌体专用蛋白裂解液,解决条带弥散,更加均一的蛋白浓度,我们专为外泌体蛋白裂解研发,已经有IF=25.8分客户文献支持;
做摸索:50ml外泌体专用无血清培养基,足够您换细胞优化培养条件,节省您的试验经费;
 活动规则:买UR51102外泌体专用无血清培养基,以上礼品三选一。多买可以累加奖品。从各级代理商处拿货享受同等待遇。
活动规则:买UR51102外泌体专用无血清培养基,以上礼品三选一。多买可以累加奖品。从各级代理商处拿货享受同等待遇。
活动时间:2022年7月25日-8月31日,礼品有限,赠完为止。
*本活动解释权归Umibio品牌所有。

首先,外泌体专用无血清培养基目前客户主要应用范围是肿瘤细胞和T细胞,也有一些客户的间充质干等细胞的文章也陆续出来了。更多的应用在增加,更多的文献在发表,我们的活动也要跟上客户的脚步,我们是新时代摸着石头过河的新青年,7年得外泌体发展历程,让我们脚步愈加稳健!

1:节省成本:相比于还要买无外泌体血清,成本更低,类似于完全培养基的状态;
2:节省时间:不管是半换液还是直接全换液,都是比较方便使用的,不需要再用FBS去配置;
3:真正做到没有外泌体干扰:完全没有胎牛血清来源外泌体的干扰,科研数据更加严谨可靠,电镜背景更干净,提取出的外泌体杂蛋白更少,PS:因为有很多客户反馈无外泌体血清培养的外泌体在提取纯化过柱子的时候会堵柱子。

Umibio很贴心的为大家准备了几款可以用于相关实验的小试剂,帮您一箭双雕。
做探索:GW4869抑制剂,用于抑制外泌体的产生,配置好了,直接用,因为很多客户反馈自己在配置的时候老是溶解不好;
做鉴定:外泌体专用蛋白裂解液,解决条带弥散,更加均一的蛋白浓度,我们专为外泌体蛋白裂解研发,已经有IF=25.8分客户文献支持;
做摸索:50ml外泌体专用无血清培养基,足够您换细胞优化培养条件,节省您的试验经费;
活动时间:2022年7月25日-8月31日,礼品有限,赠完为止。
*本活动解释权归Umibio品牌所有。








